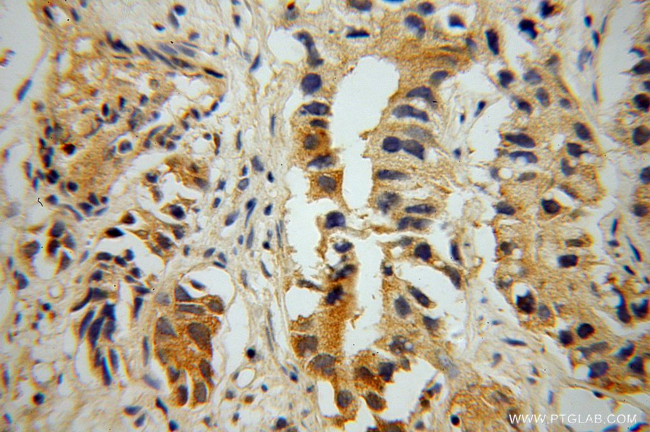
PNMA1 Antibody in Immunohistochemistry (Paraffin) (IHC (P))

Search
Proteintech
PNMA1 Polyclonal Antibody
{{$productOrderCtrl.translations['antibody.pdp.commerceCard.promotion.promotions']}}
{{$productOrderCtrl.translations['antibody.pdp.commerceCard.promotion.viewpromo']}}
{{$productOrderCtrl.translations['antibody.pdp.commerceCard.promotion.promocode']}}: {{promo.promoCode}} {{promo.promoTitle}} {{promo.promoDescription}}. {{$productOrderCtrl.translations['antibody.pdp.commerceCard.promotion.learnmore']}}
产品信息
13631-1-AP
种属反应
已发表种属
宿主/亚型
分类
类型
抗原
偶联物
形式
浓度
规格
纯化类型
保存液
内含物
保存条件
运输条件
产品详细信息
Immunogen sequence: MAMTLLEDW CRGMDVNSQR ALLVWGIPVN CDEAEIEETL QAAMPQVSYR MLGRMFWREE NAKAALLELT GAVDYAAIPR EMPGKGGVWK VLFKPPTSDA EFLERLHLFL AREGWTVQDV ARVLGFQNPT PTPGPEMPAE MLNYILDNVI QPLVESIWYK RLTLFSGRDI PGPGEETFDP WLEHTNEVLE EWQVSDVEKR RRLMESLRGP AADVIRILKS NNPAITTAEC LKALEQVFGS VESSRDAQIK FLNTYQNPGE KLSAYVIRLE PLLQKVVEKG AIDKDNVNQA RLEQVIAGAN HSGAIRRQLW LTGAGEGPAP NLFQLLVQIR EEEAKEEEEE AEATLLQLGL EGHF (1-353 aa encoded by BC039577)
靶标信息
PNMA1 encodes a protein that is highly restricted to the brain and testis. Anti-PNMA1 reacts mainly with subnuclear elements (including the nucleoli) and to a lesser degree the cytoplasm.
仅用于科研。不用于诊断过程。未经明确授权不得转售。
生物信息学
蛋白别名: 37 kDa neuronal protein; Neuron- and testis-specific protein 1; Paraneoplastic antigen Ma1; Paraneoplastic antigen Ma1 homolog; paraneoplastic Ma antigen 1; paraneoplastic neuronal antigen MA1; PNMA1; unnamed protein product
基因别名: 5730402C15Rik; MA1; PNMA1
UniProt ID: (Human) Q8ND90, (Rat) Q8VHZ4, (Mouse) Q8C1C8
Entrez Gene ID: (Human) 9240, (Rat) 170636, (Mouse) 70481